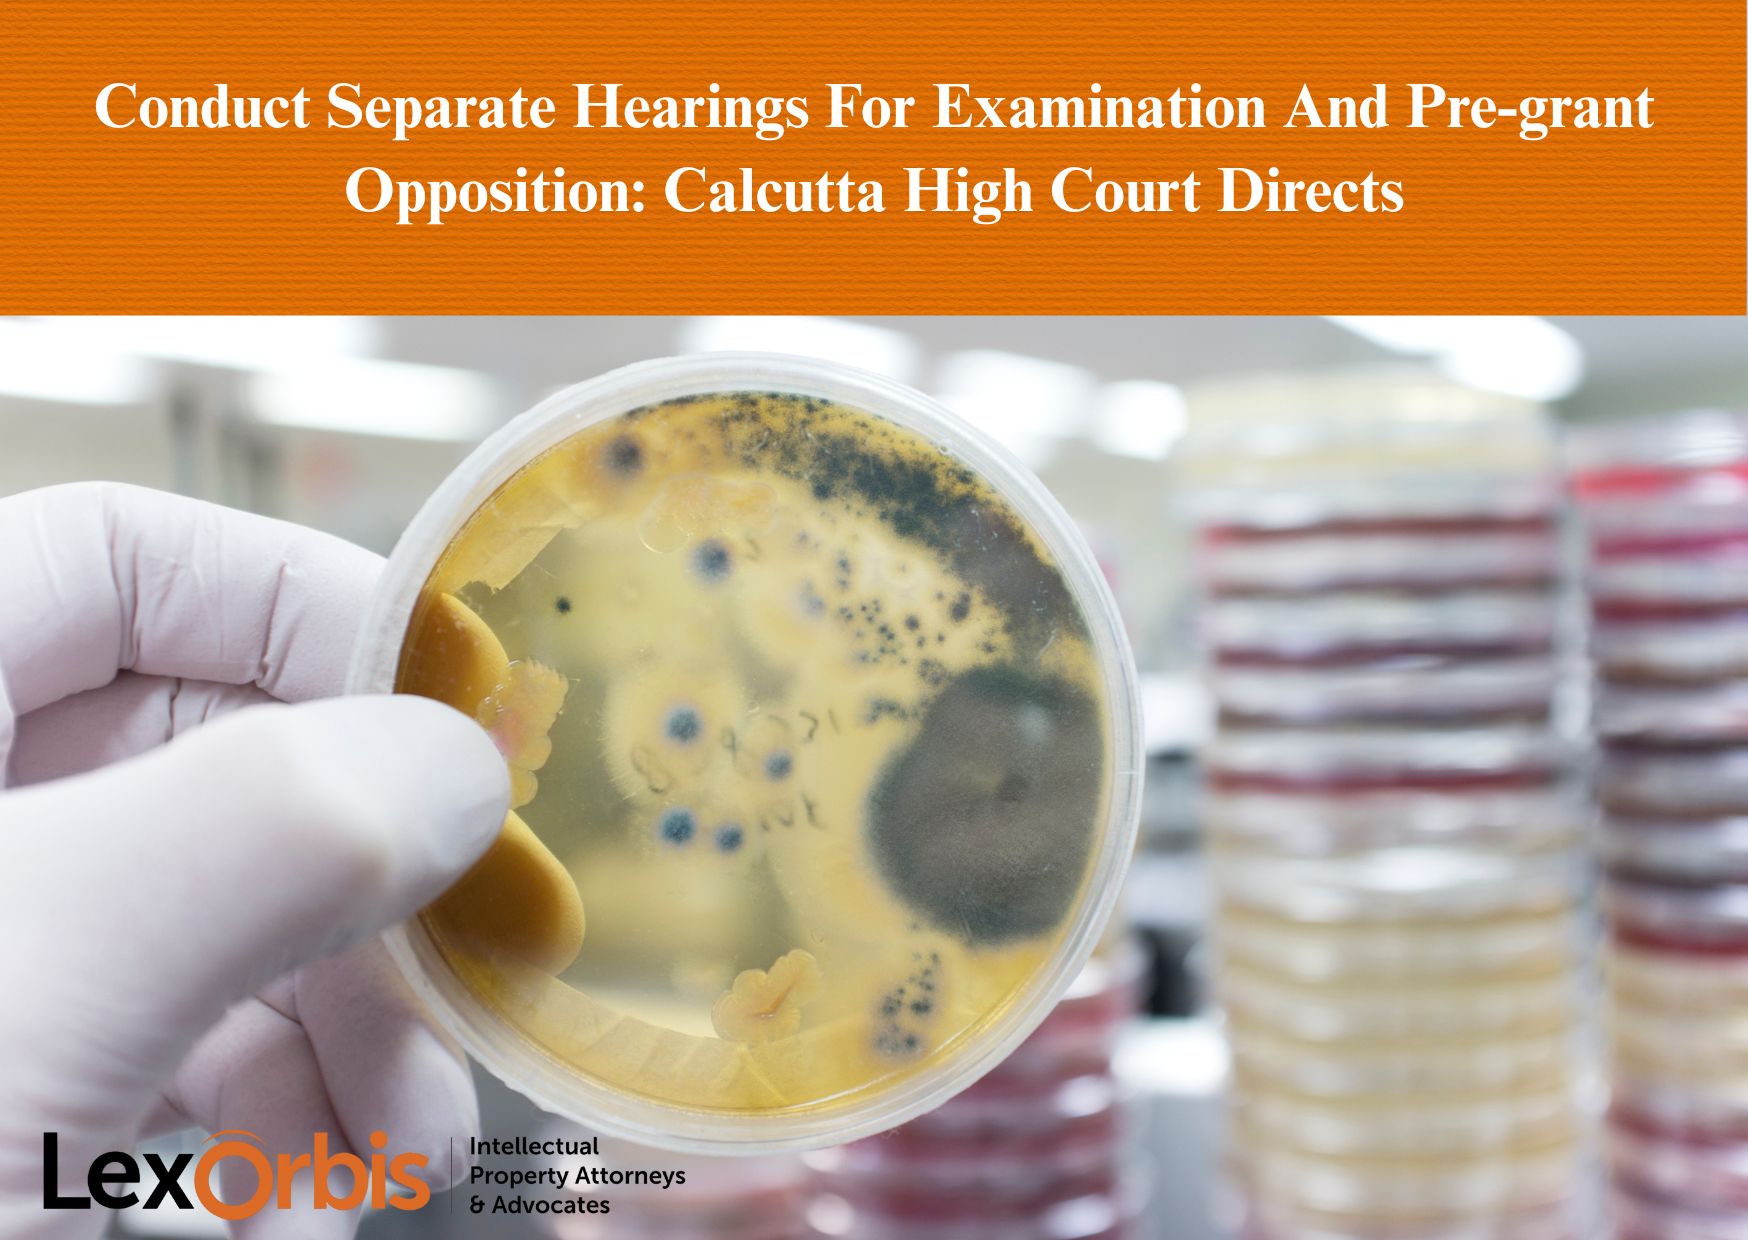
Conduct Separate Hearings For Examination And Pre-grant Opposition: Calcutta High Court Directs

News & Updates
Conduct Separate Hearings For Examination And Pre-grant Opposition: Calcutta High Court Directs
In the matter of UPL Limited vs Union of India & Ors., order dated September 16, 2025, the application for patent by UPL […]

E-commerce Platforms Accountable For Curbing Counterfeits In The Growing Digital Age
The rapid growth of e-commerce has transformed the retail landscape, providing consumers with unparalleled convenience and accessibility. However, this shift to digital platforms […]

Legal Infirmities In Refusal Of A Patent: Calcutta High Court Rules Remand Inevitable
It is known that if the Appeal Court finds that the Controller has not followed the principle of natural justice while refusing a […]

Technical Advancement Required To Secure Patent: Delhi High Court Affirms
In the case of Saint Gobain Glass France vs Assistant Controller of Patents C.A.(COMM.IPD-PAT) 13/2024, the key issue before the Delhi High Court […]
Awards & Recognitions

Managing IP – IP Stars Rankings 2025- Patent Prosecution
We are delighted to share that LexOrbis has been ranked in the Patent Prosecution category in Managing IP – IP Stars Rankings 2025. […]

Managing IP – IP Stars Rankings 2025
We are truly honoured to announce that LexOrbis has been recognised by the Managing IP – […]

IAM Patent 1000 2025
We are delighted to share that LexOrbis has been recognised in the IAM Patent 1000 2025 – The World’s Leading Patent Professionals rankings. The firm […]

World Trademark Review Global Leader 2025
We are pleased to share that Manisha Singh, Founder and Managing Partner at LexOrbis, has been recognised as a World Trademark Review Global […]







